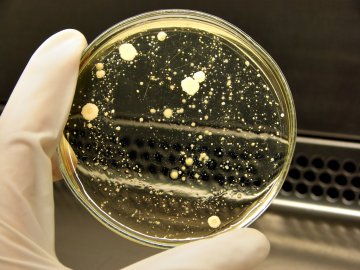
Снимка: Dreamstime

Установено е, че 3 от всеки 4 жени страдат от гъбична инфекция почти ежемесечно, което за разлика от лесно поносимите 2-3 пъти на година при останалите, е доста травмиращо.
Тези инфекции не само те карат да се чувстваш неприятно, но и създават усложнения в брака и социалния живот. И макар медицинските специалисти, обикновено да препоръчват лечение чрез антимикотици, все повече са хората, които подкрепят теорията, че най-добрата превенция, а и лечение на гъбичните инфекции, се крие в коригиране на хранителния режим на жените.
"Candida albicans"
Най- често атакуващите човешкия организъм гъбички са "Candida albicans" (понякога наричана монилия). Те обикновено се появяват по кожата и лигавиците като влагалище, уста, или ректум, но могат да се придвижват и чрез кръвта и да засягат гърлото, червата, сърцето и сърдечните клапи.
Точно като всички останали гъбички, те предпочитат захарни среди. Именно заради това при човешкото тяло може да се направи същото наблюдение, както при производството на бира и хляб. Ако диетата на жената е богата на прости захари и рафинирани въглехидрати, то тя предоставя на дрождите на Candida albicans прекрасна среда за развитие, което води до чести гъбични инфекции.
Също така този лош режим на хранене, в комбинация със стреса отслабват имунната система на жената и така усложняват проблема, защото оставят гъбичните клетки да растат необезпокоявани от защитите на организма.
Друг фактор, причиняващ чести гъбични инфекции е прекаляването с антибиотици. Заедно с вирусите и лошите бактерии, тези вещества убиват и добрите бактерии, които са отговорни за подтискането на Candida albicans в женското тяло.
Диета за елиминиране на гъбични инфекции
Жени, които са усвоили специфичен метод на хранене, формулиран с цел да прекъсне размножаването на гъбичните дрожди, се радват на успех при елиминирането на инфекциите за дълго. Те успяват да променят „средата" в тялото си на такава, неблагоприятна за гъбичките.
„Анти гъбичната" диета предполага жените да избягват захарта и рафинираните въглехидрати, да възстановят „добрите" бактерии в организма, заздравява имунната система и включва натурални антимикотични вещества. Това по всяка вероятност означава да се подложите на някои ограничения, но щом веднъж разпространението на гъбичките е било елиминирано, приемът на храна може да се нормализира.
Жените, които имат нещастието да страдат често от микозни инфекции, може би не е зле да помислят за такава генерална промяна в ежедневието си и да се опитат да минималиизират посещенията при доктора. Освен това, намаляването на сладките неща в нашата диета има и много приятния страничен ефект на влизане в по-фина форма.

Наталия Киселова: Не съм изненадана от поведението на Борисов
Наталия Киселова: Не съм изненадана от поведението на Борисов  Българка грабна международна награда за уникален портрет на соколар
Българка грабна международна награда за уникален портрет на соколар  Рецепта от тефтера на баба: Бързи хлебчета
Рецепта от тефтера на баба: Бързи хлебчета  Филип Буков откровено за преследването на актьорството и мечтаната роля
Филип Буков откровено за преследването на актьорството и мечтаната роля 
 Магнитни бури през ноември 2025 г.: Кои са най-опасните дати
Магнитни бури през ноември 2025 г.: Кои са най-опасните дати  2024 г. вероятно е била най-горещата в последните 125 хил. години
2024 г. вероятно е била най-горещата в последните 125 хил. години  Пробив в създаването на диаманти с помощта на електрони
Пробив в създаването на диаманти с помощта на електрони  В Китай се готвят да изстрелят ракетата Long March 2F с пилотирана мисия Shenzhou 21
В Китай се готвят да изстрелят ракетата Long March 2F с пилотирана мисия Shenzhou 21 
 Националка на България аут от битка за 100 000 долара в Мексико
Националка на България аут от битка за 100 000 долара в Мексико  Всички резултати и класирания в НХЛ
Всички резултати и класирания в НХЛ  Аморим призна, че е имал съмнения за бъдещето си в Юнайтед
Аморим призна, че е имал съмнения за бъдещето си в Юнайтед  ЦСКА 1948 цака Левски за голяма звезда
ЦСКА 1948 цака Левски за голяма звезда 
 Любовен хороскоп за 3 – 9 ноември
Любовен хороскоп за 3 – 9 ноември  Дневен хороскоп за 1 ноември, събота
Дневен хороскоп за 1 ноември, събота  Протеинови палачинки с извара
Протеинови палачинки с извара  3 картини разкриват какво ви очаква през ноември
3 картини разкриват какво ви очаква през ноември 
 Откриха нови сигнали в мозъка, чрез които се диагностицира Паркинсон
Откриха нови сигнали в мозъка, чрез които се диагностицира Паркинсон  Кои храни са най-вредни за мозъка?
Кои храни са най-вредни за мозъка?  Как да разпознаем инфекциозна мононуклеоза в детска възраст?
Как да разпознаем инфекциозна мононуклеоза в детска възраст?  Какво е козметичен фастинг и защо набира популярност?
Какво е козметичен фастинг и защо набира популярност? 
 дава под наем, Тристаен апартамент, 105 m2 Варна, Левски, 650 EUR
дава под наем, Тристаен апартамент, 105 m2 Варна, Левски, 650 EUR  дава под наем, Двустаен апартамент, 75 m2 Варна, Център, 1000 EUR
дава под наем, Двустаен апартамент, 75 m2 Варна, Център, 1000 EUR  дава под наем, Тристаен апартамент, 68 m2 Варна област, м-т Ален Мак, 434.6 EUR
дава под наем, Тристаен апартамент, 68 m2 Варна област, м-т Ален Мак, 434.6 EUR  дава под наем, Тристаен апартамент, 143 m2 София, Полигона, 900 EUR
дава под наем, Тристаен апартамент, 143 m2 София, Полигона, 900 EUR 
 Остави коментар
Остави коментар
 rkn
( преди 13 години )
rkn
( преди 13 години )